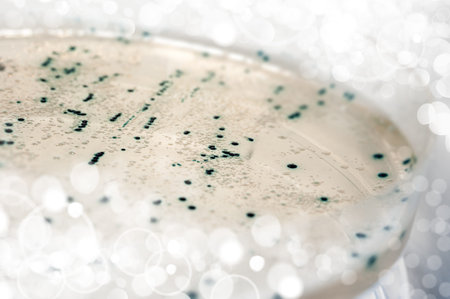
Agar plate with bacterial colonies transformed with plasmid DNAの写真素材

写真素材 - Agar plate with bacterial colonies transformed with plasmid DNA
作品情報
Agar plate with bacterial colonies transformed with plasmid DNA
- ID:21635536
- 作品種別:写真
- 作者名:Anna Ivanova
キーワード
- agar
- agar agar
- amplification
- bacterial
- bacterial colonies
- bacterial colonies
- bacterium
- biotech
- blue
- blue white selection
- cloning
- colonies
- control
- dish
- disposable
- e coli
- genetic modification
- genetically modified organism
- genetics
- isolated
- microbal
- microbiology
- modification
- molecular biology
- mutagenesis
- mutation
- petri dish
- pharma
- plastic
- protection
- research
- sample
- science
- selection
- yellow
- bacteria
類似作品
Backgrounds of ...
Laboratory tech...
some pearls wit...
Study Colony ch...
Bacterial cultu...
Backgrounds of ...
Backgrounds of ...
Backgrounds of ...
Backgrounds of ...
Backgrounds of ...
Backgrounds of ...
Yeast in petri ...
Antimicrobial s...
Agar plate with...
Backgrounds of ...
Backgrounds of ...
chemist wearing...
Backgrounds of ...
Backgrounds of ...
Bacteria growin...
Helicobacter py...
Close up the me...
Petri dish with...
Escherichia col...
Backgrounds of ...
Colonies of bac...
Doctor holding ...
E coli bacteria...
Bacterial cultu...
Colony of bacte...
Backgrounds of ...
Gloved hands of...
bacterial colon...
Colonies of bac...
The real coloni...
The germs in th...
Abstract ink te...
Medical technic...
Bacterial colon...
A researcher ca...
Foos safety pat...
Bacteria growin...
Petri dishes
Transparent and...
Bacterial colon...
Bacterial cultu...
Macro View of A...
Close-up of bac...
Texture of natu...